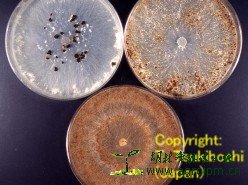

About Thanatephorus cucumeris
发布日期:2014-01-18 15:03
来源:网络
作者:网络
浏览次数:
以下资料来自:http://www.niaes.affrc.go.jp/inventory/microorg/eng/z21e-Rhiz-sola.html
Thanatephorus cucumeris (Frank) Donk [=Rhizoctonia solani Kühn]
 |
 |
|
|
Hyphae (under fluorescens) |
Hyphae (nuclei staining) |
Colony appearance (upper left: AG1 IA, upper light: AG1 IB, lower: AG2-2 IIIB) |
Morphology:
Teleomorph: Producing sterigmata on basidia of doliform to short clavate. On stigma, producing basidiospores hyaline, broad ellipsoidal to obovate, smooth, 6-14 x 4-8 um in size.
Anamorph: Hyphae pale brown to brown, branching nearly at right angles, slightly constricted at the point of branching, 6-10 um in width, without clamp connections and conidia.
以下资料来自:http://www.cals.ncsu.edu/course/pp728/Rhizoctonia/Rhizoctonia.html
Rhizoctonia solani, the most widely recognized species of Rhizoctonia was originally described by Julius Kühn on potato in 1858. Rhizoctonia solani is a basidiomycete fungus that does not produce any asexual spores (called conidia) and only occasionally will the fungus produce sexual spores (basidiospores). In nature, R. solani reproduces asexually and exists primarily as vegetative mycelium and/or sclerotia. Unlike many basidiomycete fungi, the basidiospores are not enclosed in a fleshy, fruiting body or mushroom. The sexual fruiting structures and basidiospores (i.e. teleomorph) were first observed and described in detail by Prillieux and Delacroiz in 1891. The sexual stage of R. solani has undergone several name changes since 1891, but is now known as Thanatephorus cucumeris.
以下资料来自:http://www.plantmanagementnetwork.org/pub/php/brief/2006/rsolani/

Rhizoctonia solani AG1-IA isolate from soybean in South Carolina. Note large dark brown sclerotia that developed in concentric circles within 7 days after transfer to APDA.